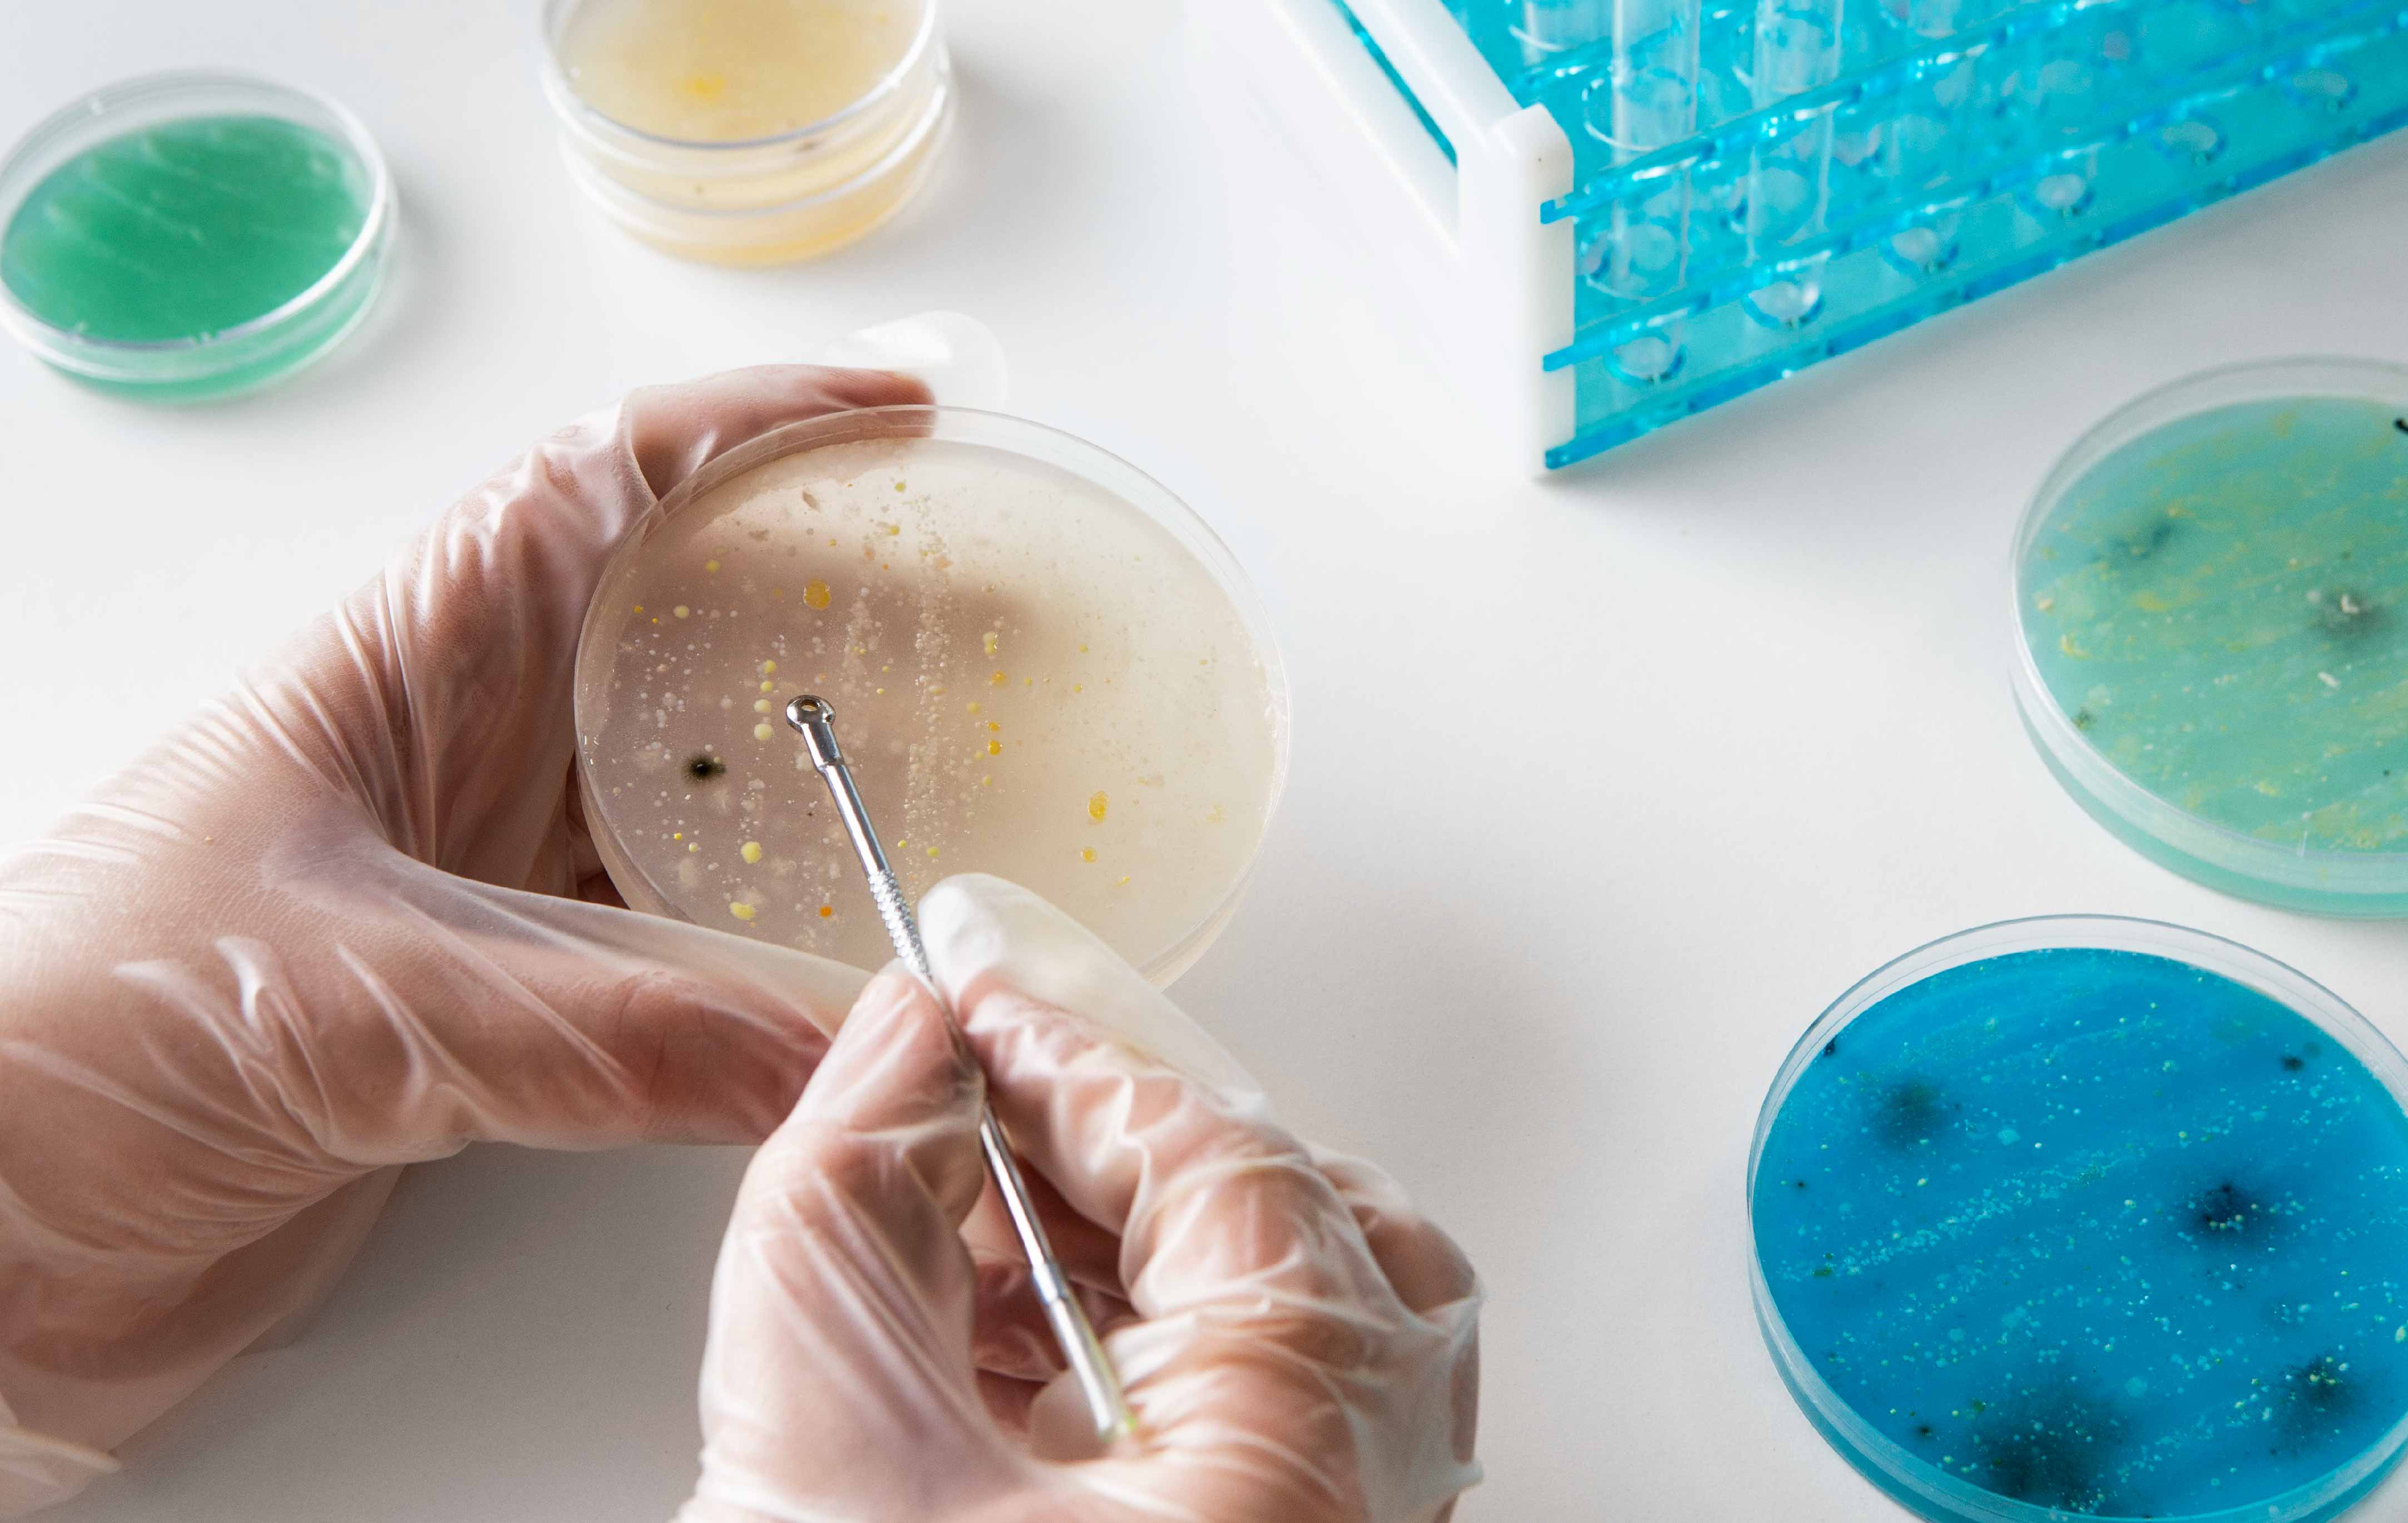

菌株工程与优化
通过基因改造与高通量筛选,实现菌株性能的突破性提升基因编辑与改造采用合成生物学与精准基因编辑工具,优化微生物菌株,提高目标产物的合成效率。高通量筛选与优化构建菌株或者酶的突变文库,开发快速筛选方法,利用高通量筛选平台高效筛选高性能突变体,可实现快速迭代突变和筛选,极大提高研发效率。
基于多组学智能调控的
合成生物技术解决方案
我们以智能研发系统为基础,利用BT+IT双驱动,加速研发进程,缩短产品开发周期,优化成本,快速实现商业化落地。
菌株工程与优化

发酵工艺开发与优化

应用测试与验证

产物分离与纯化服务

强劲的研发与产品管线储备